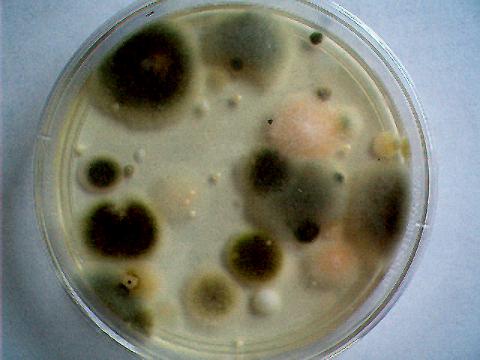

|
Java Games: Flashcards, matching, concentration, and word search. |
 |
 |
The Fungus Among Us!
Complete and smile! Created by Jeff Reed
|
| A | B |
I am a plant,  | I have true roots, stems, and leaves |
I am a mushroom,  | I am a fungi with a stalk and cap |
I am yeast,  | I am a fungus in all breads. |
I am slime!,  | I am a fungus that grows miles long |
I am bracket fungi,  | I live off dead or sick tree bark |
I am mold (no roots, stems, leaves), | I can be helpful or DEADLY |
I am yummy Yogurt,  | I am full of good mold |
I am yummy cheese,  | I make pizza moldy! |
I am lichen,  | I am fungi and algae living together |
I am how plants make food,  | My talent is never found in fungi |
|
 |
|
|
|
Sag Harbor Elementary School |
| Sag Harbor, NY |
|
|
|
|
|
| |